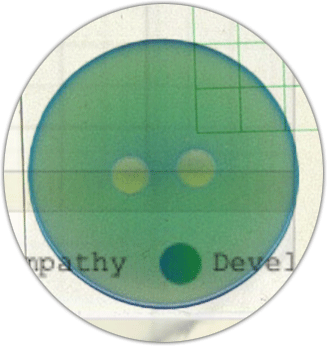
Sound Button

Analytical vs Embodied: Data-driven calculation vs. physical/emotional presence.
Temporal vs Atemporal: Connected to time flow vs. outside time constraints.
Contextual vs Decontextualized: Grounded in context vs. context-free.
Intuitive vs Computational: Natural/effortless vs. calculated/algorithmic.
The "uncanny valley" occurs when AI interaction is close to human-like but not quite there--creating a sense of unease or discomfort.